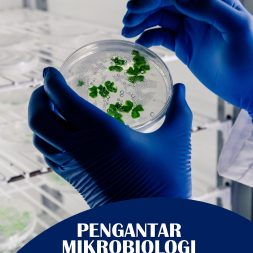
PENGANTAR MIKROBIOLOGI LINGKUNGAN:  Mikroba Di Sekitar Kita

-

INTERNET OF THINGS (IOT) UNTUK PENGHEMATAN SUMBER DAYA ENERGI LISTRIK
-

KELELAHAN KERJA: Musuh Keselamatan dan Produktivitas
Rp79.000 -

PANDUAN GURU DALAM MENGOPTIMALKAN ARTIFICIAL INTELLIGENCE (AI) UNTUK MENUNJANG PEMBELAJARAN
-

PENERAPAN PRINSIP PRODUCT LIABILITY DALAM PENYELESAIAN SENGKETA KONSUMEN
-

Cara Biasa Aja, Bisa Sukses Kok! Jalan Sukses yang Biasa Aja
-
PENGANTAR MIKROBIOLOGI LINGKUNGAN: Mikroba Di Sekitar Kita
-

BIOKIMIA DASAR
-

HARMONI PENGELOLAAN SUMBER DAYA ALAM DAN PEMBANGUNAN BERKELANJUTAN